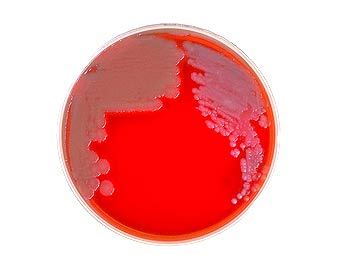

|
Бактерии сибирской язвы. Фото с сайта textbookofbacteriology.net
|
Случай заболевания сибирской язвой выявлен в Алтайском крае. Житель села Маралиха Краснощековского района был госпитализирован 10 августа. К настоящему времени специалисты подтвердили диагноз "сибирская язва", сообщает РИА Новости со ссылкой на пресс-службу ГУ МЧС РФ по Алтайскому краю.
Ситуация контролируется МЧС, заявил сотрудник пресс-службы, отметив, что состояние больного удовлетворительное и его жизни ничто не угрожает.
Предполагается, что мужчина мог заразиться на личном подворье при убое коровы, у которой был обнаружен возбудитель сибирской язвы. В связи с этим на территории села Маралиха введен карантин.
Новых случаев заболевания людей и животных не выявлено, добавили в МЧС.







